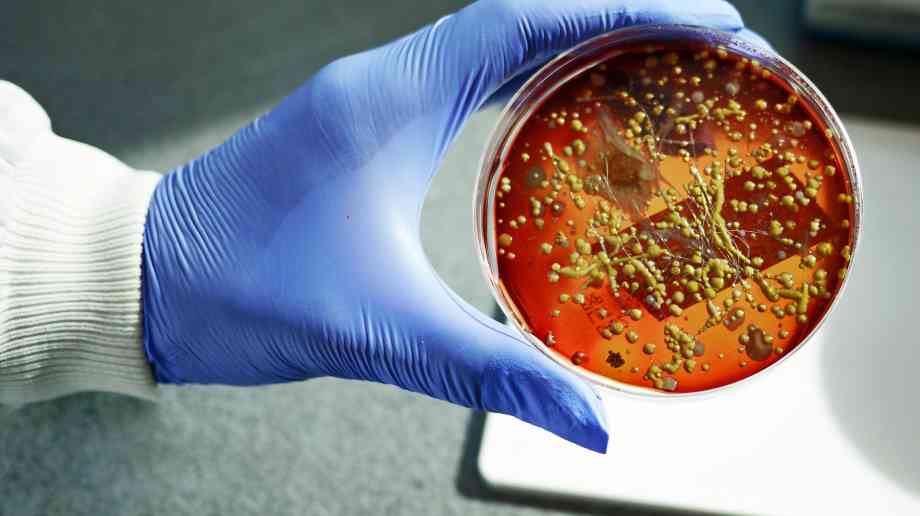

This story was first published in digitalhealth.net
With Public Health England predicting that increasing antibiotic resistance could lead to 10 million deaths by 2050 worldwide, plus leading economist Lord Jim O’Neill saying it could cost the global economy $100 trillion, reducing Healthcare-Associated Infections (HCAIs) can only be achieved by NHS estate managers being more open to technology that provides innovative property solutions. Dr. Michail Karavolos, technical manager for BioCote Ltd, explains why
The current HCAI regime of infection prevention and control strategies (including hand hygiene, cleaning and training procedures) has long proven to be ineffective. According to the European Centre for Disease Prevention and Control, this contributes to 37,000 attributable deaths in Europe each year, plus annual financial losses of approximately €7 billion in Europe and 16 million extra days of hospital stay required, according to the World Health Organisation.
What’s more, the built environment is playing a major part in spreading the infection. Healthcare settings particularly, along with other highly populated environments, are a breeding ground because of shared facilities and enclosed environments, circulated air, common contact surfaces and extended mixing. Common disinfectants have limited residual effects and bacterial populations are rapidly displaying increased resistance to them.
BioCote Silver Ion Antimicrobial Technology makes all kinds of surfaces inhospitable to pathogenic microorganisms. It has a multi-modal action and is effective against a wide range of leading superbugs (including MRSA and ESBL-producing E. coli, Clostridium difficile and Klebsiella pneumoniae, plus carbapenemase-producing Enterobacteriaceae or CPE) destroying up to 99.99 per cent of bacteria, fungi (including invasive Candida species) and even viruses like H1N1 and H7N9 - through proven protein and oxidative damage, membrane disruption and DNA interference.
Along with Acinetobacter and Pseudomonas, CPE has been classed as the most ‘critical’ group of bacteria by the WHO, because it poses a particular threat in hospitals, nursing homes, and among patients whose care requires devices such as ventilators and blood catheters. CPE also encompasses the likes of Escherichia, Shigella and Salmonella and having been evidenced to survive for many months on hard surfaces can cause sometimes deadly, infections like septicaemia and pneumonia.
Antimicrobial technology
With the numbers of antibiotic resistant bacteria continuing to grow, current methods to control them are increasingly limited. However, antimicrobial technology can successfully be combined with thorough hand-washing practices and regular cleaning to minimise cross-contamination and become an essential and proactive element of healthcare infection control.
Because it does not wear out or wipe off surfaces, it can provide a continuous decontamination effect and in a ‘live’ 18-month hospital case study, BioCote antimicrobial protected materials regularly demonstrated reductions in bacteria of up to 98 per cent. Indeed, results also indicated lower numbers of bacteria on other untreated surfaces too, due to the fact there are fewer bacteria being transferred – so using a number of antimicrobial objects in hygiene conscious settings even helps reducing the chance of pathogen spread to the wider untreated environment and causing disease.
Since antimicrobials first appeared, there is now the capacity to treat a plethora of material types and silver ions especially with their very high efficacy and non-toxic properties can quite easily be manufactured into plastics, polymers, paints, textiles, fabrics, ceramics, paper, board and many other materials. Lots of real data is also available from surfaces prevalent in a host of environments, confirming that the efficacy of antimicrobial technology in real-life healthcare settings is comparable with that shown in laboratory validation testing.
Healthcare facilities looking to adopt the technology should choose a product containing a regulated antimicrobial that is compliant with BPR/EPA regulations, plus the additive contained within the product needs to be appropriate for the market sector. It should also be continuously quality control tested to guarantee high levels of antimicrobial performance - and not just during the initial development of the treated product/surface/material.
The additive manufactured into the product is best supplied by an experienced and trusted antimicrobial solutions provider too, while the product has to be correctly labelled in line with the classifying, labelling and packaging guidelines for treated articles.
Dr Karavolos says: “Even hospitals and healthcare facilities with a restricted budget can benefit, because apart from being environmentally and ecologically acceptable and completely harmless to people, it’s surprisingly cost effective and affordable too – simply integrated into any product or surface at the time of manufacture.
“If a facility was to embark on a refurbishment program of a particular department they could quite simply make a big starting difference with antimicrobial treated paint. Key touch points, like door handles, soap dispensers, grab rails, etc, could also be cost effectively converted and as this type of technology significantly reduces the potential for stains and odours caused by microbes, it also keeps susceptible medical products fresher for longer and makes them much more hygienic.
“Granted, antimicrobial technology doesn’t remove the need for regular cleaning, but it is the best complementary strategy - with integrated antimicrobial protection providing a much more comprehensive and robust solution to contamination within hospitals, schools, care homes and an array of other highly populated environments.”
This story was first published in digitalhealth.net
UK Building Regulations highlight toxic gas and smoke from layers of paint built up over multiple redecorations as a major cause of permanent ill health or death in a building fire.
Their concern rose with discovery the flame retardant paints most widely used paint along escape routes have been ones which to this day counter-productively use emission of heavy toxic gas to smother flames which rapidly spread along walls if layers of paint delaminate in a fire.
Northwich’s Victoria Infirmary (VIN) Community Diagnostic Centre (CDC) has enabled more patients
Adveco, the commercial hot water specialist, announces the launch of live metering of domestic ho
Sarah Greenslade, public affairs and communications officer at the British Parking Association looks at some of the problems and innovations in healthcare parking
It’s easy to assume that the comms team is there to handle press enquiries and the occasional social media storm – but the reality is that strategic communications can make a measurable impact across the entire organisation, from operational to financial, when done properly